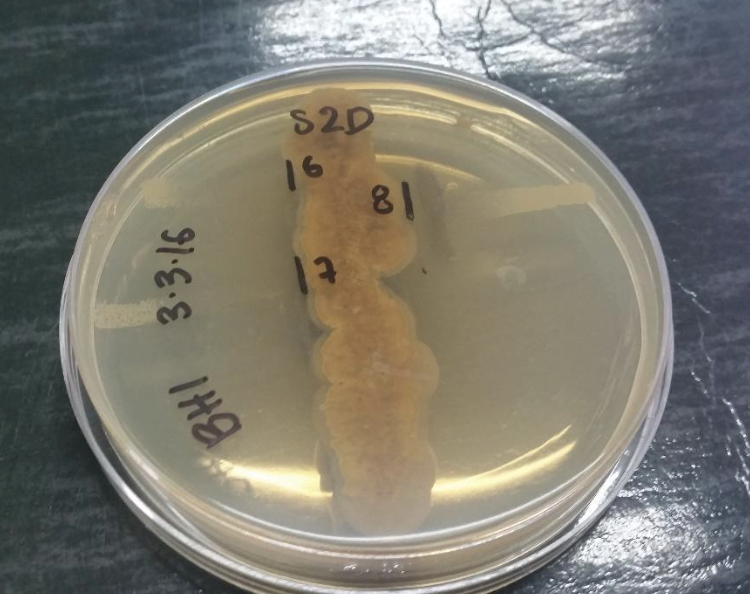

Grupo de estudio: Antibióticos y Control Biológico
Grupo de estudio de la Facultad de Ciencias de la Salud
docentes coordinadores: Víctor Manuel Osorio
Objetivos
- Fortalecer estrategias extracurriculares para la profundización de temas vistos en el aula de clase relacionados con el control biológico y la producción y actividad de antibióticos de origen natural
- Motivar en los estudiantes de Biotecnología y de Bacteriología y laboratorio clínico el estudio de técnicas utilizadas para determinar la actividad antimicrobiana
- Apoyar el desarrollo de proyectos de investigación a través de una revisión continua de los resultados publicados en artículos científicos y en la literatura relacionada.
Descripción
Este grupo se creó por iniciativa de los investigadores asociados al proyecto “Producción de compuestos con actividad antimicrobiana por fermentación en estado sólido con hongos filamentosos y actinomicetos nativos”, quienes buscaban articular actividades de investigación como apoyo a la docencia y como estrategia extracurricular para profundizar en el estudio de la producción de antibióticos y del control biológico. Se diseñó principalmente para estudiantes con interés en investigación quienes son acompañados cada semestre por docentes con experiencia en dicha línea.
Metodología
-Reuniones semanales de una hora.
-Discusión de artículos científicos liderada por uno de los integrantes del grupo.
-Presentación de avances logrados en proyectos de investigación alineados con el grupo.
-Preparación y exposición preliminar de ponencias en póster.
Resultados obtenidos
Lectura y discusión de artículos científicos:
Preparación de ponencias orales y en póster presentadas en diferentes eventos:
Impacto generado
Vinculación de estudiantes y docentes de los programas Biotecnología y Bacteriología y laboratorio clínico:
Propuestas de investigación de estudiantes del grupo presentadas desde el semillero SIFACS para financiación en convocatoria interna:
- Evaluación de la capacidad inhibitoria de aislados nativos de Streptomyces sobre Candida spp, resistentes y no resistentes a antimicóticos. Melissa Arango. Aprobado en convocatoria 2014.
- Evaluación de la capacidad de Paecilomyces nativos para el control de nemátodos causantes de enfermedades en cultivos vegetales. Daniel Andrés López. Aprobado en convocatoria 2014.
- Capacidad antimicrobiana, nematicida y citotóxica de extractos pigmentados producidos por Serratia marcescens. Daniel Carrascal. Presentado en convocatoria 2014.
- Evaluación de la capacidad antimicrobiana de Streptomyces nativas frente a hongos de importancia clínica y agrícola. Jessica Obando. Aprobado en convocatoria 2015.
- Citotoxicidad de un extracto con actividad antimicrobiana de Streptomyces sobre células animales. Julián Pineda. Presentado en convocatoria 2015.
- Producción de un pigmento antimicrobiano con Serratia marcescens usando polvo de maní como sustrato y diferentes concentraciones de glucosa. Julián Pineda. Aprobado en convocatoria 2016.
- Evaluación del efecto inhibitorio de los aceites esenciales de Tomillo (Thymus vulgaris) frente a los hongos Colletotrichum causante de la enfermedad de las cerezas del café (Cbd) y Hemileia vastatrix causante de Roya. Mario Jaramillo. Aprobado en convocatoria 2017.
Apoyo a curso de extensión:
- Fundamentos sobre nemátodos fitopatógenos. Canal Youtube Colmayor. https://www.youtube.com/watch?v=xZ5WECibavQ&t=534s
- Taller actividad antifúngica de bacterias y extractos vegetales.
Descripción del fortalecimiento, la solución o el mejoramiento de la práctica social
Gracias a las reuniones periódicas del grupo, muchos estudiantes han mejorado la lectura de artículos científicos y han afianzado la presentación oral de resultados de investigación. Establecer una conversación con los docentes y otros compañeros sobre temas asociados con la producción de antibióticos y el control biológico permite a los estudiantes generar ideas que más adelante pueden materializarse en una propuesta de investigación. Al menos cinco proyectos de investigación derivados de ideas propuestas por estudiantes tras su paso por el grupo de estudio han sido presentados desde el Semillero SIFACS y aprobados para financiación. Gracias a estos proyectos derivados de conversaciones al interior del grupo se han generado también estrategias de extensión las cuales se espera que puedan tener cada vez más alcance a la comunidad en general.